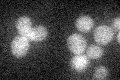
YML005W
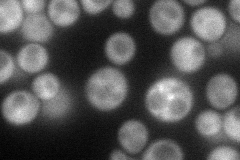
YML005W
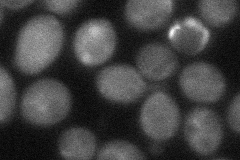
YML005W
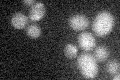
YML005W
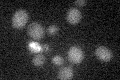
YML005W

View description
S-adenosylmethionine-dependent methyltransferase of the seven beta-strand family; required for wybutosine formation in phenylalanine-accepting tRNA
Localization:
Intensity:
Fold change:
Significance:
-
C’ GFP library in SD
below threshold18.02 -
N' NOP1pr-GFP in SD
cytosol75.671 -
N' TEF2pr-mCherry in SD

cytosol105.479 -
N' NATIVEpr-GFP in SD

below threshold17.3407 -
N' TEF2pr-VC and Cyto-VN in SD
cytosol42.4085 -
C’ GFP library in SD+DTT

cytosol20.991.16No -
C’ GFP library in SD+H2O2
cytosol20.971.16No -
C’ GFP library in Starvation Media
cytosol18.051No -
C’ GFP library on the background of Pup2-DaMP

below threshold -
C’ GFP library on the background of CCT mutant

below threshold17.55790.973893No
